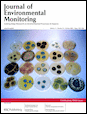
Inside front cover

Inside front cover
Abstract
The first page of this article is displayed as the abstract.

We are excited to let you know that our journals content will be migrating to the Silverchair platform, with a planned launch in summer 2026.
All of our content will still be hosted at pubs.rsc.org and the new platform will provide a more intuitive reading and navigation experience, along with improved discovery and indexing of your work.
Details on the move can be found in our partnership announcement.
The first page of this article is displayed as the abstract.
Please wait while we load your content...
Something went wrong. Try again?
Please wait while we load your content...
Something went wrong. Try again?
J. Environ. Monit., 2009, 11, 1710 DOI: 10.1039/B919375H
To request permission to reproduce material from this article, please go to the Copyright Clearance Center request page.
If you are an author contributing to an RSC publication, you do not need to request permission provided correct acknowledgement is given.
If you are the author of this article, you do not need to request permission to reproduce figures and diagrams provided correct acknowledgement is given. If you want to reproduce the whole article in a third-party publication (excluding your thesis/dissertation for which permission is not required) please go to the Copyright Clearance Center request page.
Read more about how to correctly acknowledge RSC content.
 Fetching data from CrossRef.
Fetching data from CrossRef.
This may take some time to load.
Loading related content
